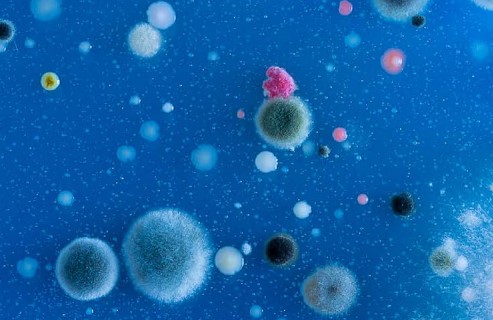

Contenido principal
Alfa 63
La radioterapia avanza hacia el futuro con tecnologías como la protonterapia o la terapia FLASH. Estos tratamientos son el tema de apertura de la entrega de otoño de la revista Alfa que se adentra también en la astrobiología, disciplina que reúne biología, química, física, geología y astronomía para abordar una pregunta fundamental: ¿qué es la vida y dónde puede existir? Alfa apunta, además, hacia algunos de los grandes retos que marcan la agenda internacional: la geoingeniería. El perfil histórico se detiene en esta ocasión en Niels Bohr, figura que revolucionó la física con sus teorías sobre la estructura atómica y la dinámica nuclear, pero también advirtió sobre las implicaciones políticas y éticas de la ciencia. En la entrevista, Alfa charla con Alfredo Poves, maestro de varias generaciones de físicos nucleares y pionero en el estudio del modelo de capas. Las páginas más técnicas de la revista del CSN incluyen un artículo sobre los veinticinco años del Protocolo de la chatarra y hacen balance sobre la renovación de la autorización de explotación de la central nuclear Trillo.
El apartado de I+D describe el proyecto sobre la caracterización, exhalación y remediación de radón en materiales de construcción (EXRADON), a través de un estudio de la Universitat Politècnica de València. Este número sirve, además, para conocer mejor la labor del complejo de laboratorios de Seibersdorf del Departamento de Ciencias y Aplicaciones Nucleares del OIEA desde su apertura en 1962.
¿Hay vida más allá de la Tierra?
Origen de la vida: límites y posible existencia en el universo
¿Estamos solos en el universo? La pregunta, tan antigua como la humanidad, ha dejado de ser solo asunto de filósofos y escritores de ciencia ficción. La astrobiología, disciplina joven en plena expansión, trata de ofrecer respuestas con rigor científico.
El objetivo principal de cualquier rama de la ciencia es responder a interrogantes que plantea el universo y la naturaleza. La astrobiología no es una excepción. Ciencia interdisciplinar que combina biología, química, física, geología y astronomía, explora una de las cuestiones que más han inquietado a la humanidad desde sus inicios: la vida. «Su objetivo es comprender cómo, a partir de procesos fisicoquímicos, pudieron surgir las condiciones que dieron lugar a la vida en la Tierra, y explorar la posibilidad de que exista en otros mundos», indica Eva Villaver, subdirectora del Instituto de Astrofísica de Canarias.
No obstante, es necesario reflexionar sobre las características de lo que se consideran seres vivos. «Podría parecer suficiente examinar las formas de vida terrestres y elaborar una lista de sus propiedades comunes, suponiendo que estas nos revelan lo esencial de la vida. Sin embargo, los organismos terrestres comparten muchas características que probablemente no sean fundamentales, sino heredadas de un ancestro común. Un ejemplo claro es el uso de ADN como molécula de alma cenamiento de información genética. ¿Significa esto que cualquier forma de vida debe poseer ADN? En mi opinión, no necesariamente. Lo esencial es que exista una molécula capaz de almacenar la información genética para el mantenimiento y reproducción de la vida», explica Ester Lázaro, jefa del departamento de Evolución Molecular del Centro de Astrobiología (CSIC-INTA). De este modo, «una estructura puede considerarse viva si es capaz de transformar energía con base en una información genética que le permita evolucionar».
El origen de la vida
Hace unos 3800 millones de años, la Tierra era un planeta muy distinto al actual, con una intensa actividad geológica y una atmósfera compuesta principalmente por nitrógeno, dióxido de carbono, hidrógeno y metano. No obstante, el planeta reunía las condiciones necesarias para que pudiera desarrollarse la vida: era lo suficientemente grande como para retener el calor interno y permitir la tectónica de placas, contaba con atmósfera y tenía agua líquida. «Esto depende de la estrella en torno a la que orbita. Para que no experimente variaciones extremas que pongan en peligro la evolución de la vida, la estrella no puede va - riar demasiado su energía en esca - las de miles de millones de años, lo que significa que no puede ser mu - cho más grande que el Sol. Además, mantener una atmósfera requiere una estrella que no sea demasiado activa, que no emita grandes can - tidades de altas energías en poco tiempo», afirma Villaver. 
La Tierra contaba con estas condi - ciones y en ella ya estaban presen - tes muchos de los componentes químicos esenciales para el sur - gimiento de la vida. «Hoy en día, numerosos experimentos de labo - ratorio han demostrado que exis - ten múltiples vías posibles para la formación de las moléculas básicas que componen los seres vivos. Lo que aún desconocemos es cuál –si es que fue alguna de ellas– tuvo lu - gar en la Tierra primitiva», indica Lázaro.
Durante los primeros centenares de millones de años, la interacción entre el agua y los minerales del manto terrestre, así como la pre - sencia de energía en forma de luz ultravioleta, generaron condiciones propicias para la aparición de mo - léculas precursoras de la vida que, poco a poco, evolucionaron hasta volverse más complejas y especia - lizarse en funciones determinadas.
Existen diversas hipótesis –como la síntesis prebiótica, la pansper - mia o el ARN, entre otras– que in - tentan explicar cómo se dio esta evolución hasta llegar a la vida ce - lular. A pesar de que son diferentes, todas coinciden en que, en algún momento, ciertas moléculas adqui - rieron la capacidad de replicarse y evolucionar. «La adaptación bioló - gica –o evolución, en términos más amplios– es el proceso mediante el cual los seres vivos cambian a lo largo del tiempo para ajustarse me - jor a su entorno», explica Lázaro. «En la vida terrestre, este proceso ocurre gracias a que la información genética, contenida en el ADN, puede experimentar modificacio - nes que se transmiten a la descen - dencia. Así, se generan poblaciones | r ep o r taje | | 1 6 6 3 a l f a con individuos distintos entre sí, cada uno con características que pueden hacerlo más o menos apto para sobrevivir y reproducirse en determinadas condiciones ambientales. Los cambios en el ADN pueden ser pequeños, pero también existen cambios más drásticos que, en ocasiones, dan lugar a grandes innovaciones evolutivas».
Condiciones extremas
No todos los organismos han prosperado en un medio que, en principio, se consideraría apropiado, sino que algunos pueden sobrevivir en ambientes y condiciones casi incompatibles con la vida, de modo que, según Villaver, «son extremadamente útiles para entender los rangos en los que la vida podría ser posible en otros planetas». Los denominados extremófilos –la mayoría microscópicos– «no han reinventado la vida para adaptarse a estos entornos, sino que han ajustado sus proteínas, sus membranas y sus mecanismos celulares para que funcionen en condiciones que, para otros organismos, serían destructivas», añade Lázaro.
Uno de esos lugares hostiles para la vida es el río Tinto, en Huelva. Sus aguas, de color rojo escarlata y con un pH muy ácido, son ricas en metales, pero también en azufre. En este entorno, semejante al que se puede encontrar en Marte –y, por tanto, un análogo perfecto para estudiar cómo podría desarrollarse la vida en otros planetas–, la NASA y el Centro de Astrobiología han llevado a cabo una serie de investigaciones en las que han detectado microorganismos adaptados a estas condiciones. «Uno de los hallazgos más sorprendentes ha sido la detección de cianobacterias vivas y capaces de realizar la fotosíntesis a más de seiscientos metros de profundidad, en completa oscuridad y en un ambiente con escasos nutrientes», indica Lázaro. También se han detectado bacterias capaces de sobrevivir a la radiación en entornos como los reactores nucleares.
Estos descubrimientos abren la posibilidad de que, con unas condiciones semejantes, en otros planetas se hayan dado las reacciones químicas necesarias para que existan formas de vida adaptadas a medios que, desde nuestro punto de vista, son hostiles.
La vida en el universo
La existencia de vida en el universo cuenta con argumentos tanto a favor como en contra. Se afirma que es una cuestión de estadística: ante los cientos de trillones de planetas y lunas que existen –tanto en la Vía Láctea como en otras galaxias–, algunos reúnen las condiciones necesarias para que la vida se desarrolle; no obstante, no se han encontrado biomarcadores y son muchos los factores que deben coincidir en tiempo y en espacio para que surja la vida. 
El primer requisito es que el planeta se encuentre dentro de la zona habitable de su estrella. Esta zona es «la región en torno a una estrella donde el agua puede existir en forma líquida en la superficie de un planeta. Depende de la cantidad de energía que recibe de la estrella, por lo que tiene una dependencia tanto de la distancia a la que se encuentra la estrella como de su tamaño», explica Villaver. Estar en la zona habitable no garantiza la existencia de vida, pero es una condición necesaria para que puedan darse procesos biológicos similares a los que ocurren en la Tierra.
Además, se necesita la suficiente diversidad de elementos químicos que den comienzo a la vida –vida que, como prueban los organismos extremófilos, es más resistente de lo que se creía–. El hallazgo de moléculas orgánicas en meteoritos demuestra que esos elementos existen en el cosmos de manera abundante.
«El meteorito ALH84001, encontrado en la Antártida y originario de Marte, generó un gran debate en los años noventa al sugerirse que contenía fósiles de bacterias marcianas, hipótesis que hoy se considera poco probable. Más recientemente, los rovers Curiosity y Perseverance han encontrado moléculas orgánicas en la superficie marciana que, aunque no prueban la existencia de vida, podrían ser la base a partir de la cual esta podría haberse desarrollado en el pasado», explica Lázaro. Además, fuera del sistema solar también se han encontrado otras moléculas que plantean varias incógnitas. «En 2020 se anunció la posible detección de fosfina –sustancia asociada a procesos biológicos en la Tierra– en la atmósfera de Venus, aunque estudios posteriores han puesto en duda esta observación. Más recientemente, se ha informado de la presencia de dimetil sulfuro (DMS) en la atmósfera de un exoplaneta, una molécula que en la Tierra está vinculada a la actividad microbiana marina. Sin embargo, no podemos asegurar que su origen fuera de la Tierra sea biológico», admite Lázaro.
Gracias a los biosensores –dispositivos que combinan elementos biológicos con tecnología–, se pueden detectar biofirmas o señales de vida en otros planetas. Estos biosensores ya se utilizan para analizar la superficie de Marte y podrían usarse en misiones a lunas como Europa. En concreto, este satélite de Júpiter cuenta con la presencia de agua, tanto en forma de hielo como en la de un océano líquido bajo esa capa. En estas condiciones, podrían encontrarse compuestos que indiquen actividad biológica, tal como ocurre en la Tierra, donde existen organismos que habitan ambientes similares. En esos entornos, la energía no proviene del Sol, sino de fuentes hidrotermales y reacciones químicas. «La certeza solo la tendremos el día en que logremos encontrar una prueba concreta. Por eso, la búsqueda resulta tan relevante: porque, en este momento, no contamos con ninguna seguridad absoluta, solo con hipótesis y posibilidades que guían nuestra exploración. Encontrar vida en otro lugar, además de la Tierra, nos permitiría afirmar con absoluta certeza que las posibilidades de vida en el universo son infinitas», indica Villaver.
No obstante, las formas de vida que podrían encontrarse fuera de la Tierra dependerán tanto de las condiciones ambientales como del tiempo durante el cual haya actuado la evolución. «Si tomamos como referencia nuestro propio planeta, veremos que durante la mayor parte de su historia la vida estuvo representada exclusivamente por microorganismos. La aparición de formas más complejas fue un proceso lento y dependiente de circunstancias muy específicas, que quizás no se hayan repetido en otros rincones del universo», plantea Lázaro. «Si la vida surge en otros mundos, es estadísticamente más probable que lo haga y permanezca en formas microbianas simples, dado que estas requieren menos condiciones específicas y son más resilientes a entornos extremos», añade Villaver.
¿Dónde podrían encontrarse? Además de en las lunas heladas de Júpiter y Saturno, Marte también es buen candidato. Los indicios sobre la existencia de agua salobre y algunas moléculas orgánicas encontradas indican que podrían darse procesos biológicos en el planeta rojo. «La búsqueda de vida más allá de la Tierra se organiza principalmente en dos aproximaciones complementarias. La primera se centra en el estudio in situ de los cuerpos de nuestro sistema solar, a través del envío de sondas robóticas a lugares cercanos como Marte, o las lunas de los planetas gigantes como Europa o Encélado para analizar la composición del terreno, la atmósfera y, en algunos casos, el subsuelo en busca de señales biológicas. La segunda aproximación se orienta hacia el estudio de mundos lejanos, los llamados exoplanetas, empleando telescopios y técnicas de observación avanzadas que nos permiten caracterizar a distancia sus propiedades físicas: tamaño, masa, temperatura, atmósfera o incluso la presencia de moléculas en sus atmósferas», señala Villaver.
Sin embargo, este no es el único desafío al que se enfrenta la astrobiología. «Quizá el reto más profundo sea encontrar otro ejemplo de vida con un origen distinto al terrestre. Si algún día logramos descubrir una forma de vida que no comparta nuestra historia evolutiva, podríamos por fin entender qué es lo esencial, lo universal, lo inevitable en la vida. Quizá entonces podríamos empezar a responder no solo cómo es la vida, sino qué significa», concluye Lázaro. «La astrobiología no es solo una ciencia que busca vida en otros mundos, sino una forma de mirar con asombro la vida en el nuestro».
Descarga la revista completa